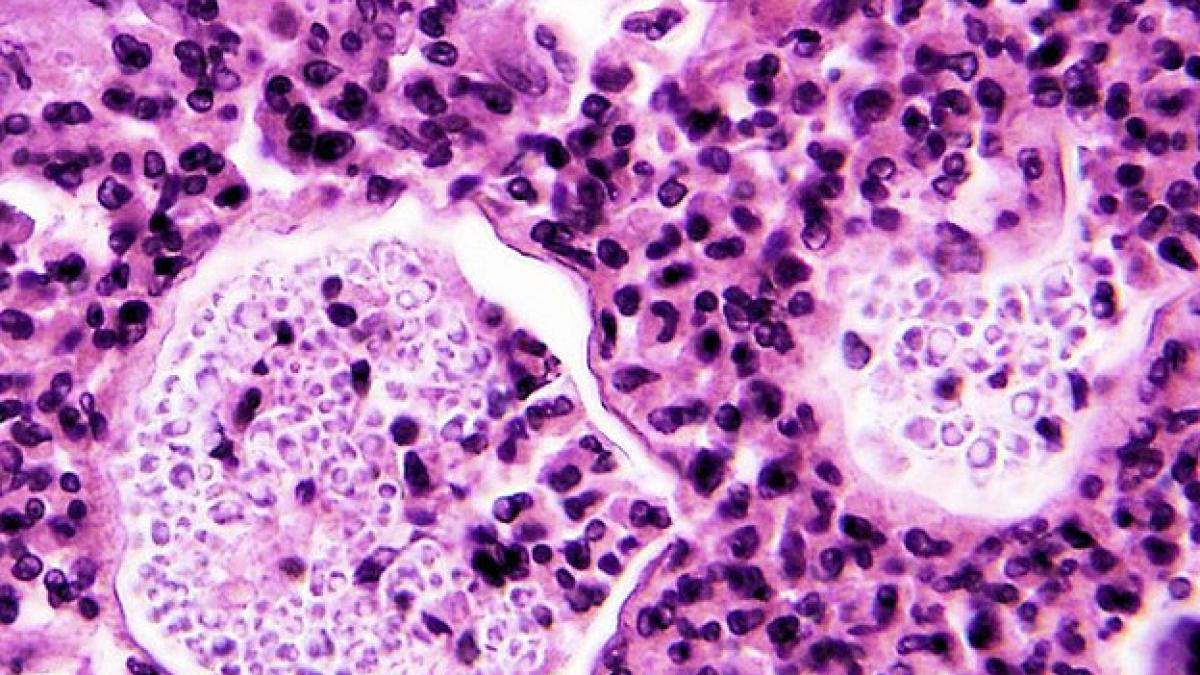
medicamentul care aduce boala americanii sunt speriati si se confrunta cu cea mai mare epidemie din

Antena 3 CNN
›
boala
boala | Pagina 12
Eşti pe pagina 12 din 13 a ultimelor ştiri despre boala publicate pe Antena 3.
Eşti pe pagina 12 din 13 a ultimelor ştiri despre boala publicate pe Antena 3.